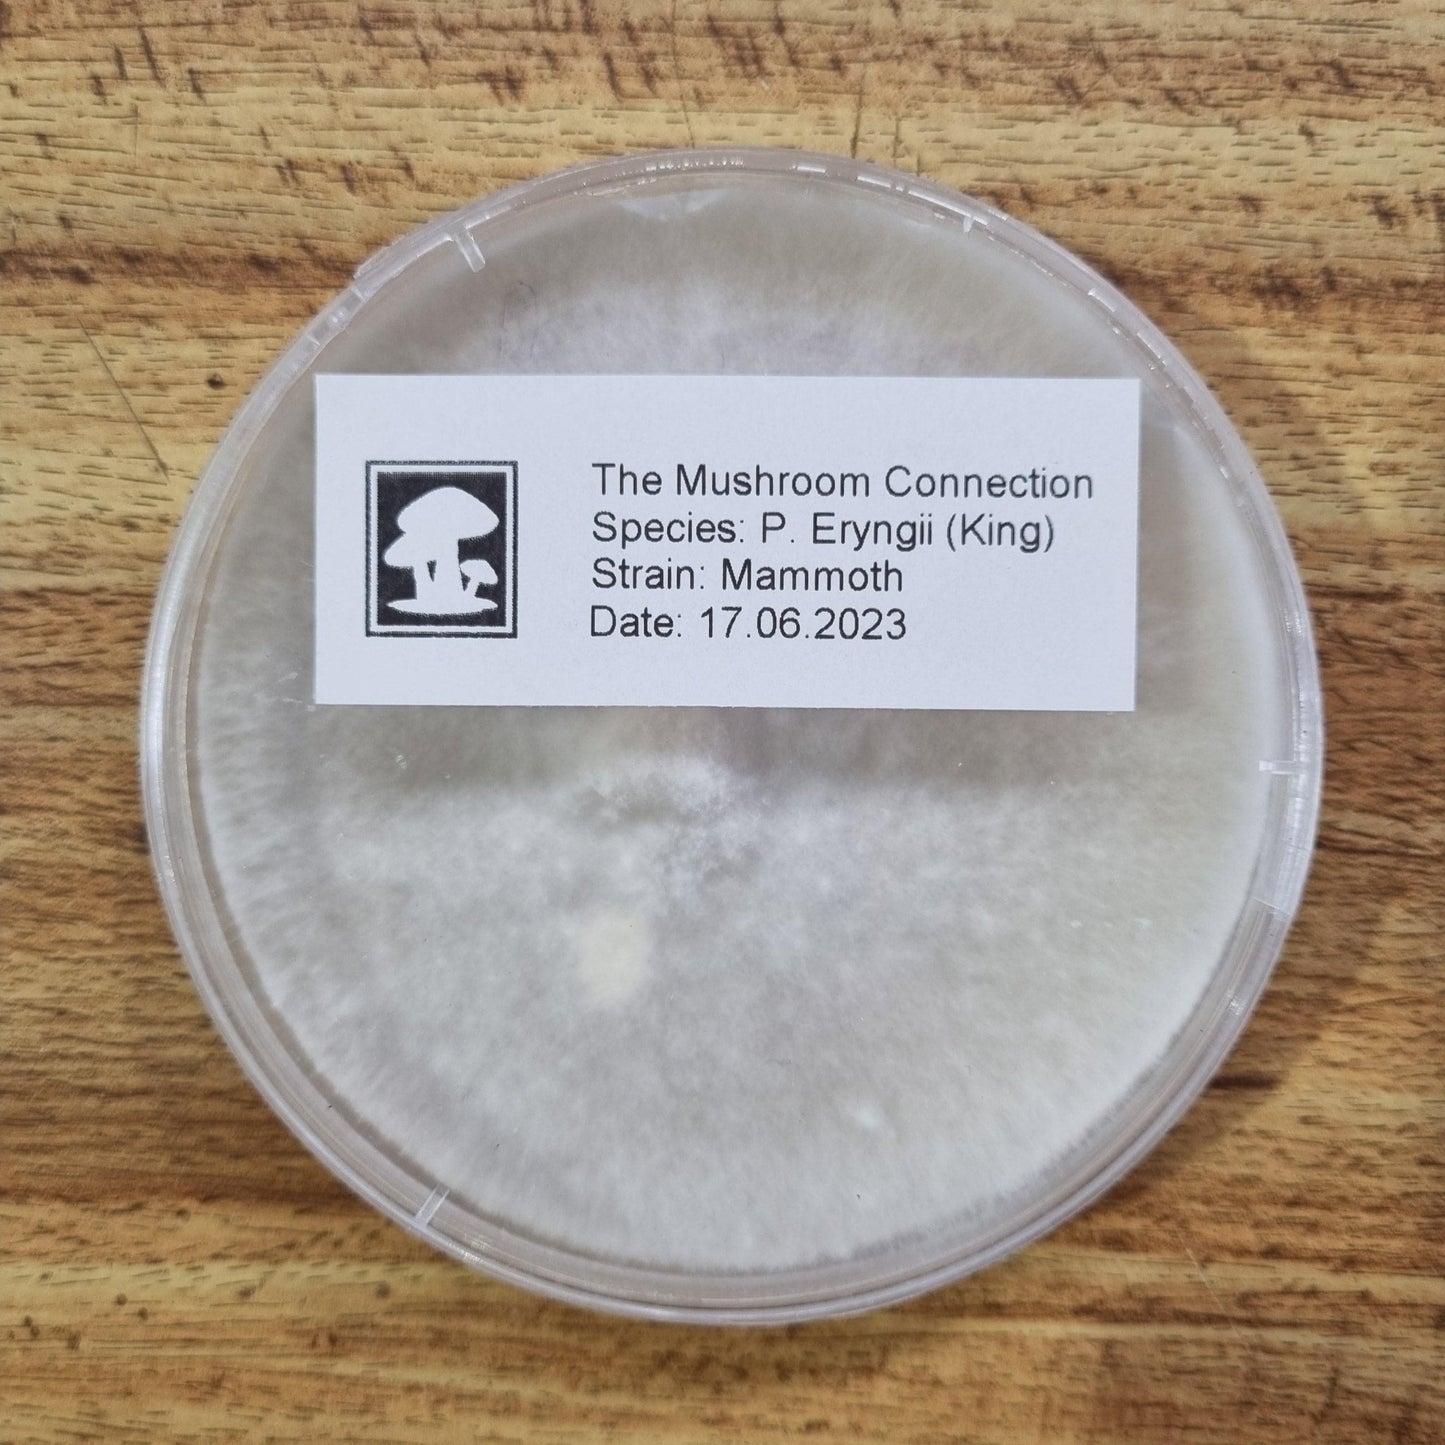

1
/
of
2
The Mushroom Connection
King Brown "Mammoth"
King Brown "Mammoth"
Regular price
$70.00 AUD
Regular price
Sale price
$70.00 AUD
Unit price
/
per
Tax included.
Shipping calculated at checkout.
Couldn't load pickup availability
Share